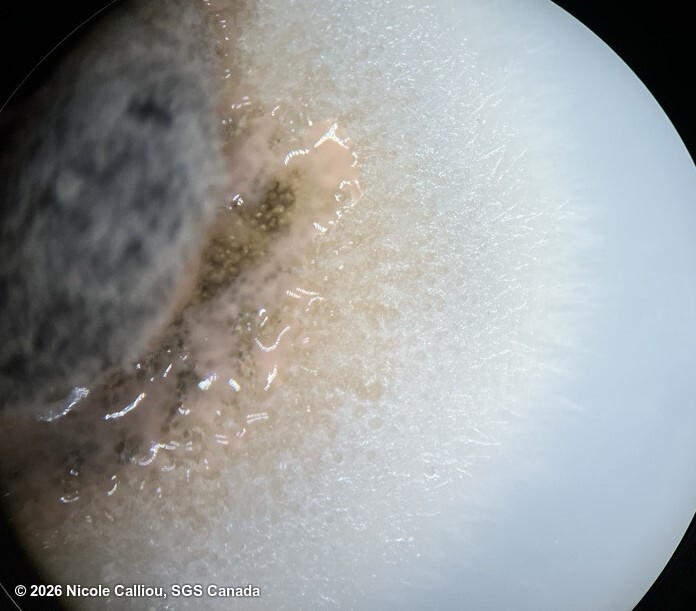
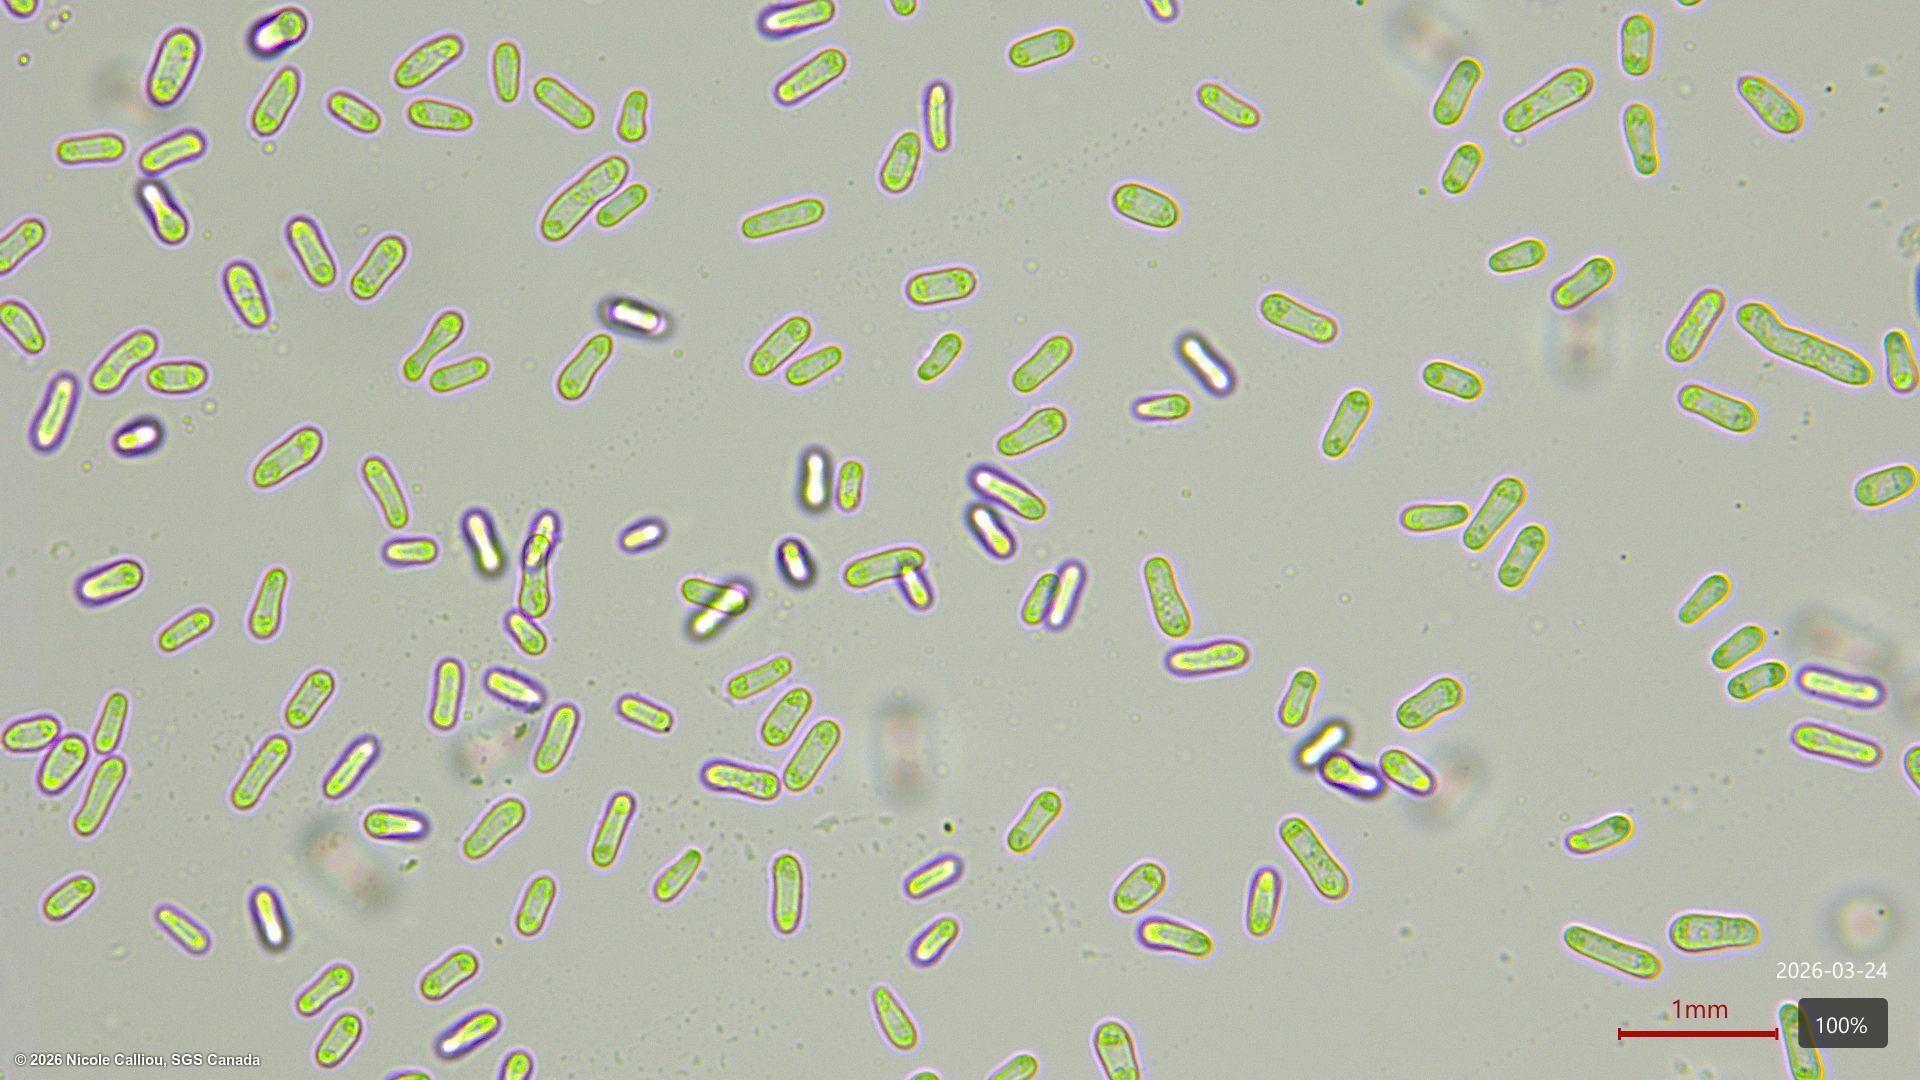

Ascochyta rabiei
Overview
|
Scientific name
|
Ascochyta rabiei |
|
Genus
|
Ascochyta |
|
EPPO code
|
MYCORA |
|
Common name
|
Chickpea Blight |
|
Synonyms
|
Mycosphaerella rabiei |
Description
From ISTA Working Sheet #38:
Growth on blotters: Mycelium scanty to moderate, light brown to pinkish and fluffy. Pycnidia submerged or superficial, with or without orange spore exudate. Pycnidiospores hyaline, straight or slightly curved, rounded at each end, many non-septate, some 1-septate, 6-16 x 3-7 μm.
From ISTA proficiency test Annex 4:
On malt-agar and PDA, mycelium develops slowly, white to green colored, development of pycnidia occurs at the surface of the substrate, they are pale brown to dark brown on both media. At 7 days, colony diameter varies between 10-35 mm.
Pycnidia immersed becoming erumpent, globose, dark brown, 140-200 μm [3], 65-245 μm [5] diam.; wall composed of 1-2 layers of elongated pseudo parenchymatic cells, ostiole 30 - 50μm [3][5] wide. Pycnidia usually release orange mucilaginous mass of pycnidiospores (cirrus).
Pycnidiospores hyaline, straight or slightly curved, (0–) 1 septate, some unicellular, slightly or not constricted at the septum, rounded at each end, 10–16 × 3–5 μm [3], 8.2-10 x 4.2-4.5 μm [5] formed from hyaline ampulliform phialides.